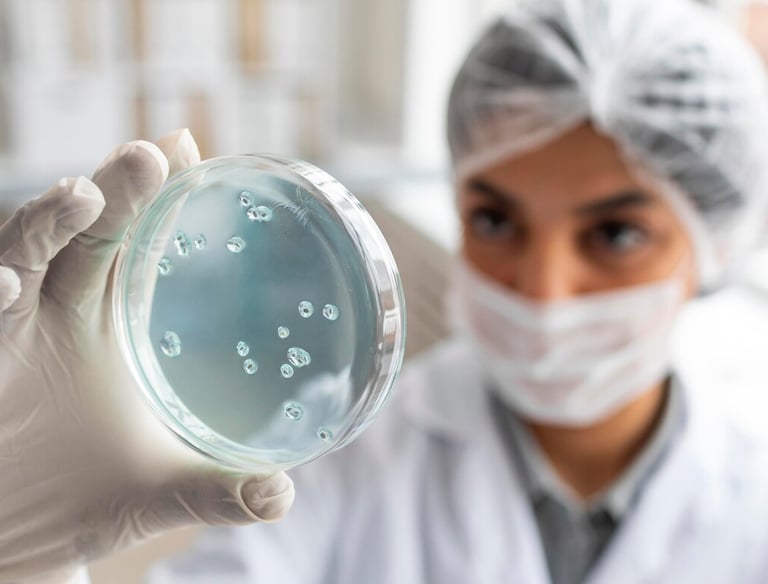
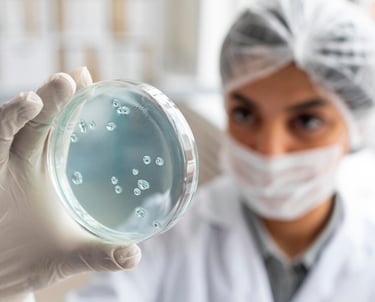

Expertise certifiée en decontamination et qualitée de l'Air
Assainissement completet securitair en pour milieux sensible par un Maitre Technicien
Elimination moleculaire des odeurs tenaces (tadac,canabis, moisissures)
Neutralisation d'odeurs
Our services
Provide a general summary of the services you provide, highlighting key features and benefits for potential clients.
TEST DE QUALITE DE L'AIR

Write a short text about your service. Highlight key benefits for potential clients.


CONTROLE DES ODEURS
Write a short text about your service. Highlight key benefits for potential clients.
Write a short text about your service. Highlight key benefits for potential clients.
Service title
Notre mission essentielle
Chez DécontaminAIR, notre mission est de transformer chaque espace intérieur en un sanctuaire de santé. Nous croyons que respirer un air pur est un droit fondamental, particulièrement pour les plus vulnérables. En tant qu'experts certifiés, nous nous engageons à éliminer les menaces invisibles avec une rigueur absolue, garantissant ainsi la sécurité et la tranquillité d'esprit de nos clients






Expertise certifiée
Nos protocoles rigoureux garantissent une décontamination profonde et des rapports détaillés.
Nos services
Des solutions précises pour un air pur et sain.
Décontamination


Nettoyage certifié des thermopompes en milieux sensibles.




Neutralisation
Forfaits intensifs pour odeurs tenaces comme tabac et cannabis.
Rapports d'air détaillés garantissant un environnement sécuritaire.
Expertise


Abonnez-vous aujourd'hui
Recevez nos conseils pour un air toujours pur